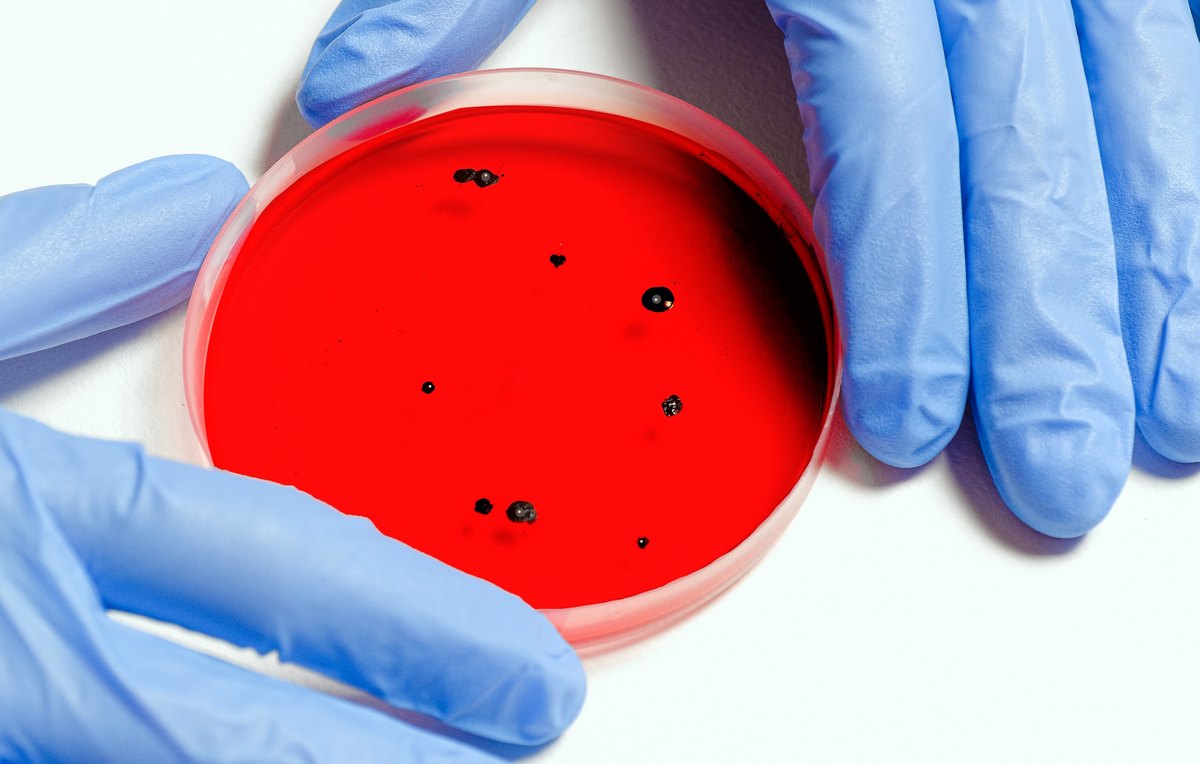
coltura

MONDO SALUTE
I "lunchtime webinars" sul Covid19 dei PhD GB Morgagni: Thoracic and pulmonary sciences
La scuola di dottorato G.B. Morgagni organizza una serie di incontri telematici di approfondimento sul Covid19, i lunchtime webinars, indirizzati a studentesse e studenti di dottorato, come anche a tutor, professori e ricercatori.
I seminari si estendono per tutto il mese di maggio e coprono diversi ambiti: Epidemiology and biostatistics, History of Medicine, Experiences of our Thoracic-Pulmonary, CardioVascular, Endocrine and Metabolic, Neuroscience Teams, during the COVID19 pandemia.
Per connettersi ai seminari: https://unipd.zoom.us/j/93306490106
Webinar ID: 933 0649 0106
- QUANDO 15 MAGGIO - ORE 13:00
- online Zoom









